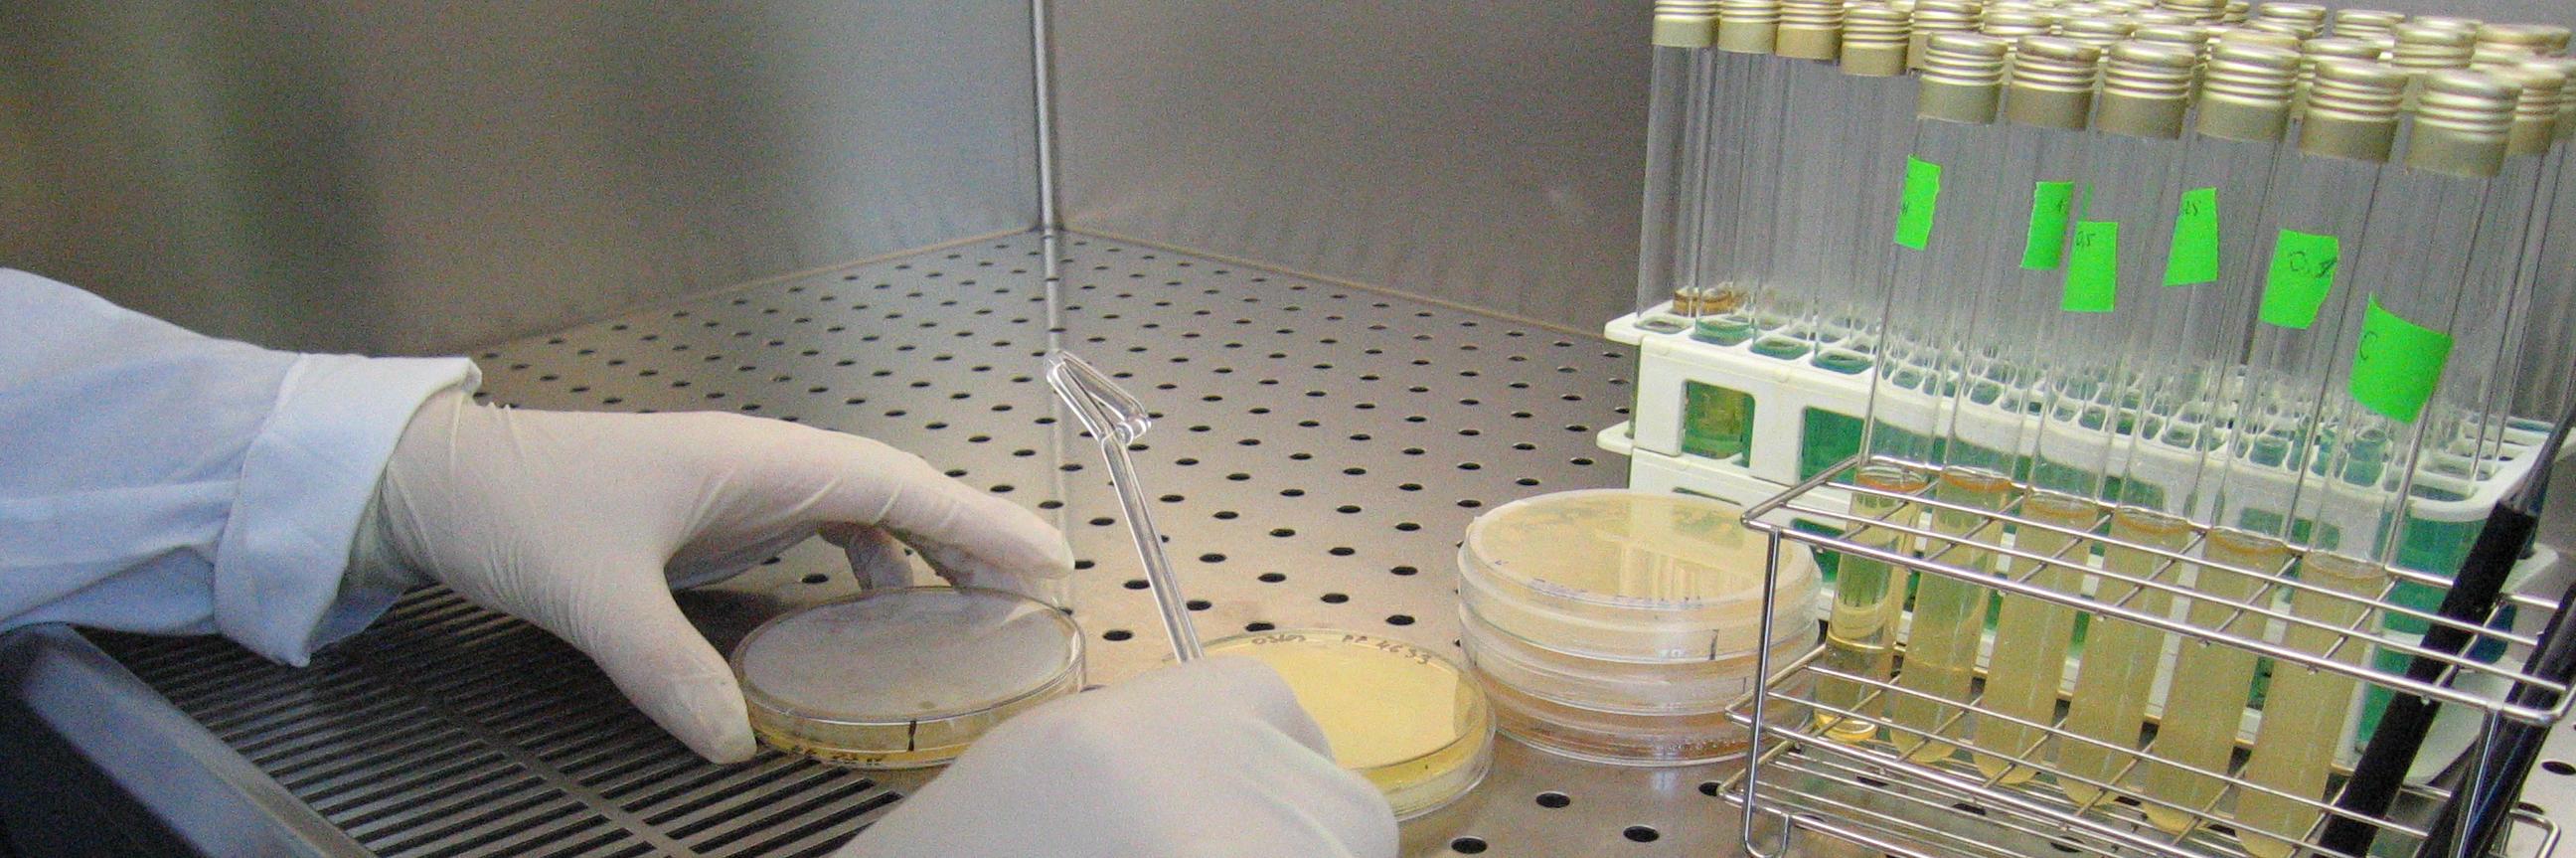
InterfibioURV banner

InterfibioURV
186 posts

@Interfibio
Research group of @deqURV @universitatURV working at the bio/material interface.













🔬Un equip investigador de la #URV ha desenvolupat un dispositiu amb un cost inferior a un euro que permetrà detectar el paràsit responsable de la tricomoniasi, una de les infeccions de transmissió sexual més comuns al món, en només 15 minuts. 👉diaridigital.urv.cat/prova-diagnost…

🌎Com seria un joc de taula sobre el canvi climàtic? La proposta "Pingüí en perill" combina experimentació i estratègia, i ha estat la guanyadora de l’Experimentathon 2025 de la #URV, una competició que per primer cop ha comptat amb equips mixts d'universitaris i estudiants de batxillerat. 👉diaridigital.urv.cat/un-joc-de-taul…












🦠 Tras la pandemia, los viajes aumentaron 🌍, y con ellos los casos de malaria y dengue, afectando a 5⃣ M de personas. Con una ayuda #CaixaImpulse Innovación, @ParoloClaudio1 desarrollará una prueba rápida y económica para detectar ambas enfermedades. 🔗 tinyurl.com/29zvue7f



